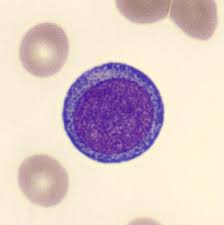
¿Qué es un proeritroblasto?

El proeritroblasto es una etapa inicial en el desarrollo de las células sanguíneas que finalmente dará lugar a los eritrocitos, también conocidos como glóbulos rojos. Para entender por qué el proeritroblasto es considerado la primera célula que puede identificarse como perteneciente a la serie eritrocítica, es importante explorar el proceso de formación de los eritrocitos y las diferentes etapas que atraviesan las células durante este proceso.
La hematopoyesis es el proceso de formación de las células sanguíneas y se lleva a cabo principalmente en la médula ósea roja. Este proceso es esencial para mantener la homeostasis y asegurar un suministro constante de células sanguíneas funcionales, incluyendo los eritrocitos. La médula ósea contiene células madre hematopoyéticas pluripotentes, también conocidas como células madre hematopoyéticas (HSC, por sus siglas en inglés). Estas células madre tienen la capacidad de diferenciarse en varios tipos de células sanguíneas, incluyendo glóbulos blancos, glóbulos rojos y plaquetas.
Cuando una célula madre hematopoyética se compromete a seguir la línea de la serie eritrocítica, se convierte en un proeritroblasto. Este compromiso se da en respuesta a señales específicas y a la regulación genética.
El proeritroblasto es una célula grande con un núcleo grande y central, así como una abundancia de citoplasma que contiene un gran número de ribosomas y organelos necesarios para la síntesis de hemoglobina. La hemoglobina es una proteína rica en hierro que permite a los eritrocitos transportar oxígeno a través del cuerpo. El proeritroblasto experimenta múltiples divisiones celulares mitóticas y cambios morfológicos durante su proceso de diferenciación y maduración. Estos cambios incluyen la reducción del tamaño del núcleo, la acumulación de hemoglobina y la eliminación de la mayoría de las estructuras celulares, como el núcleo y los organelos. A medida que avanza en su maduración, el proeritroblasto se convierte en eritroblastos, luego en reticulocitos y, finalmente, en eritrocitos maduros.
Los eritrocitos son células sanguíneas especializadas cuya principal función es transportar oxígeno desde los pulmones hasta los tejidos del cuerpo y llevar dióxido de carbono de regreso a los pulmones para su eliminación. La ausencia de núcleo y organelos en los eritrocitos maduros les permite tener más espacio para la hemoglobina y, por lo tanto, mejorar su capacidad de transporte de oxígeno.

Síguenos en X: @el_homomedicus y @enarm_intensivo Síguenos en instagram: homomedicus y en Treads.net como: Homomedicus